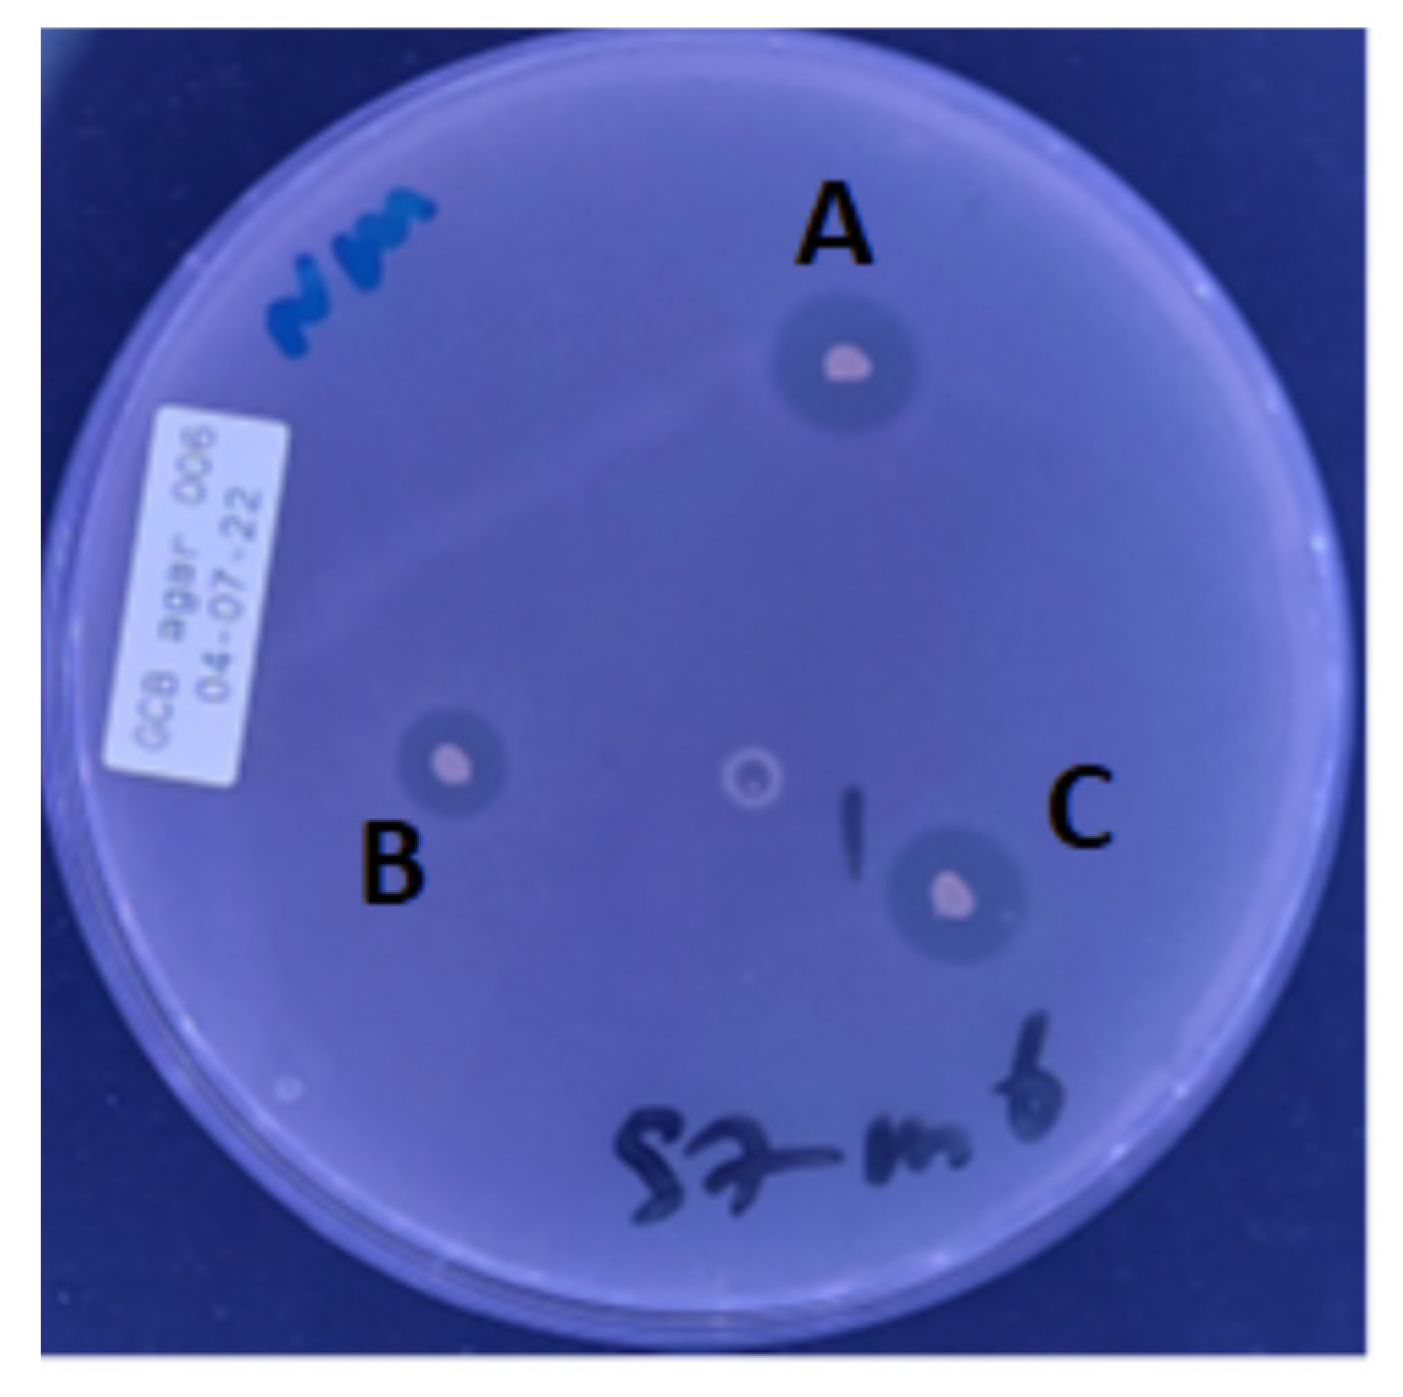

The Discovery of Oropharyngeal Microbiota with Inhibitory Activity against Pathogenic Neisseria gonorrhoeae and Neisseria meningitidis: An In Vitro Study of Clinical Isolates
Abstract
1. Introduction
2. Materials and Methods
2.1. Participants and Specimens
2.2. Origin of Pathogenic Neisseria Test Species
2.3. Identification of Inhibitory Commensals
3. Results
3.1. Isolation and Identification of Inhibitory Commensal Bacteria
3.2. Comparing the Number of Inhibitory Isolates before and after Receipt of Listerine
4. Discussion
5. Conclusions
Supplementary Materials
Author Contributions
Funding
Data Availability Statement
Acknowledgments
Conflicts of Interest
References
- Bennett, J.S.; Bratcher, H.B.; Brehony, C.; Harrison, O.B.; Maiden, M.C.J. The Genus Neisseria. In The Prokaryotes; Springer: Berlin/Heidelberg, Germany, 2014; pp. 881–900. [Google Scholar] [CrossRef]
- Coureuil, M.; Jamet, A.; Bille, E.; Lécuyer, H.; Bourdoulous, S.; Nassif, X. Molecular interactions between Neisseria meningitidis and its human host. Cell Microbiol. 2019, 21. [Google Scholar] [CrossRef]
- Hsu, K.; Ram, S.; Darville , T. Neisseria gonorrhoeae (Gonococcus). In Nelson Textbook of Pediatrics, 21st ed.; Elsevier: Amsterdam, The Netherlands, 2020; pp. 1478–1484.e1. [Google Scholar]
- Tinsley, C.R.; Nassif, X. Analysis of the genetic differences between Neisseria meningitidis and Neisseria gonorrhoeae: Two closely related bacteria expressing two different pathogenicities. Proc. Natl. Acad. Sci. USA 1996, 93, 11109–11114. [Google Scholar] [CrossRef] [PubMed]
- Unemo, M.; Bradshaw, C.S.; Hocking, J.S.; de Vries, H.J.C.; Francis, S.C.; Mabey, D.; Marrazzo, J.M.; Sonder, G.J.; Schwebke, J.R.; Hoornenborg, E.; et al. Sexually transmitted infections: Challenges ahead. Lancet Infect. Dis. 2017, 17, e235–e279. [Google Scholar] [CrossRef] [PubMed]
- Eyre, D.W.; Sanderson, N.D.; Lord, E.; Regisford-Reimmer, N.; Chau, K.; Barker, L.; Morgan, M.; Newnham, R.; Golparian, D.; Unemo, M.; et al. Gonorrhoea treatment failure caused by a Neisseria gonorrhoeae strain with combined ceftriaxone and high-level azithromycin resistance. Eurosurveillance 2018, 23. [Google Scholar] [CrossRef]
- Unemo, M.; Seifert, H.S.; Hook, E.W.; Hawkes, S.; Ndowa, F.; Dillon, J.-A.R. Gonorrhoea. Nat. Rev. Dis. Primers. 2019, 5, 79. [Google Scholar] [CrossRef]
- Kenyon, C.; van Dijck, C.; Florence, E. Facing increased sexually transmitted infection incidence in HIV preexposure prophylaxis cohorts. Curr. Opin. Infect. Dis. 2020, 33, 51–58. [Google Scholar] [CrossRef] [PubMed]
- Reilly, E.; Alfaro, J.A.; Borzelleri, A.R.; Branco, E.G.; Conklin, D.C.; Held, E.S.; Kulee, F.Z.; Kuzma, A.J.; Langdon, N.; Lasko, A.M.; et al. Draft Genome Sequences of Three Antibiotic-Producing Soil Bacteria, Staphylococcus pasteuri WAM01, Peribacillus butanolivorans WAM04, and Micrococcus yunnanensis WAM06, with Growth-Inhibiting Effects against Commensal Neisseria Strains. Microbiol. Resour. Announc. 2022, 11. [Google Scholar] [CrossRef]
- Huang, F.; Teng, K.; Liu, Y.; Cao, Y.; Wang, T.; Ma, C.; Zhang, J.; Zhong, J. Bacteriocins: Potential for Human Health. Oxid. Med. Cell. Longev. 2021, 1–17. [Google Scholar] [CrossRef]
- Dobson, A.; Cotter, P.D.; Ross, R.P.; Hill, C. Bacteriocin production: A probiotic trait? Appl. Environ. Microbiol. 2012, 78, 1–6. [Google Scholar] [CrossRef]
- Field, D.; Ross, R.P.; Hill, C. Developing bacteriocins of lactic acid bacteria into next generation biopreservatives. Curr. Opin. Food Sci. 2018, 20, 1–6. [Google Scholar] [CrossRef]
- Cooper, M.A.; Shlaes, D. Fix the antibiotics pipeline. Nature 2011, 472, 32. [Google Scholar] [CrossRef] [PubMed]
- Shtibel, R. Inhibition of growth of N. gonorrhoeae by bacterial interference. Can. J. Microbiol. 1976, 22, 1430–1436. [Google Scholar] [CrossRef] [PubMed]
- Kim, W.J.; Higashi, D.; Goytia, M.; Rendón, M.A.; Pilligua-Lucas, M.; Bronnimann, M.; McLean, J.A.; Duncan, J.; Trees, D.; Jerse, A.E.; et al. Commensal Neisseria Kill Neisseria gonorrhoeae through a DNA-Dependent Mechanism. Cell Host Microbe 2019, 26, 228–239.e8. [Google Scholar] [CrossRef] [PubMed]
- van Dijck, C.; Tsoumanis, A.; Rotsaert, A.; Vuylsteke, B.; van den Bossche, D.; Paeleman, E.; de Baetselier, I.; Brosius, I.; Laumen, J.; Buyze, J. Antibacterial mouthwash to prevent sexually transmitted infections in men who have sex with men taking HIV pre-exposure prophylaxis (PReGo): A randomised, placebo-controlled, crossover trial. Lancet Infect. Dis. 2021, 21, 657–667. [Google Scholar] [CrossRef] [PubMed]
- van Dijck, C.; Cuylaerts, V.; Sollie, P.; Spychala, A.; de Baetselier, I.; Laumen, J.; Crucitti, T.; Kenyon, C. The development of mouthwashes without anti-gonococcal activity for controlled clinical trials: An in vitro study. F1000Res 2020, 8, 1620. [Google Scholar] [CrossRef]
- Chow, E.P.F.; Williamson, D.A.; Hocking, J.S.; Law, M.G.; Maddaford, K.; Bradshaw, C.S.; McNulty, A.; Templeton, D.J.; Moore, R.; Murray, G.L.; et al. Antiseptic mouthwash for gonorrhoea prevention (OMEGA): A randomised, double-blind, parallel-group, multicentre trial. Lancet Infect. Dis. 2021, 21, 647–656. [Google Scholar] [CrossRef]
- Zoltan Fehervari. Mechanisms of Colonization Resistance. Available online: https://www.nature.com/articles/d42859-019-00018-y#author-0. (accessed on 17 June 2019).
- Caglar, E.; Kargul, B.; Tanboga, I. Bacteriotherapy and probiotics’ role on oral health. Oral. Dis. 2005, 11, 131–137. [Google Scholar] [CrossRef]
- Pavia, A.T.; Shipman, L.D.; Wells, J.G.; Puhr, N.D.; Smith, J.D.; McKinley, T.W.; Tauxe, R.V. Epidemiologic Evidence that Prior Antimicrobial Exposure Decreases Resistance to Infection by Antimicrobial-Sensitive Salmonella. J. Infect. Dis. 1990, 161, 255–260. [Google Scholar] [CrossRef]
- Fairley, C.K.; Zhang, L.; Chow, E.P.F. New thinking on gonorrhoea control in MSM. Curr. Opin. Infect. Dis. 2018, 31, 45–49. [Google Scholar] [CrossRef]
- Chow, E.P.F.; Grulich, A.E.; Fairley, C.K. Epidemiology and prevention of sexually transmitted infections in men who have sex with men at risk of HIV. Lancet HIV 2019, 6, e396–e405. [Google Scholar] [CrossRef]
- Plummer, E.L.; Maddaford, K.; Murray, G.L.; Fairley, C.K.; Pasricha, S.; Mu, A.; Bradshaw, C.S.; Williamson, D.A.; Chow, E.P.F. The Impact of Mouthwash on the Oropharyngeal Microbiota of Men Who Have Sex with Men: A Substudy of the OMEGA Trial. Microbiol. Spectr. 2022, 10. [Google Scholar] [CrossRef] [PubMed]
- Stoeken, J.E.; Paraskevas, S.; van der Weijden, G.A. The Long-Term Effect of a Mouthrinse Containing Essential Oils on Dental Plaque and Gingivitis: A Systematic Review. J. Periodontol. 2007, 78, 1218–1228. [Google Scholar] [CrossRef] [PubMed]
- Amaral, C.D.S.F.; da Silva-Boghossian, C.M.; Leão, A.T.T.; Colombo, A.P.V. Evaluation of the subgingival microbiota of alcoholic and non-alcoholic individuals. J. Dent. 2011, 39, 729–738. [Google Scholar] [CrossRef] [PubMed]
- Barb, J.; Maki, K.; Kazmi, N.; Meeks, B.; Krumlauf, M.; Tuason, R.; Brooks, A.; Ames, N.; Goldman, D.; Wallen, G. The oral microbiome in alcohol use disorder: A longitudinal analysis during inpatient treatment. J. Oral. Microbiol. 2022, 14. [Google Scholar] [CrossRef] [PubMed]
- Unemo, M.; Golparian, D.; Sánchez-Busó, L.; Grad, Y.; Jacobsson, S.; Ohnishi, M.; Lahra, M.M.; Limnios, A.; Sikora, A.E.; Wi, T.; et al. The novel 2016 WHO Neisseria gonorrhoeae reference strains for global quality assurance of laboratory investigations: Phenotypic, genetic and reference genome characterization. J. Antimicrob. Chemother. 2016, 71, 3096–3108. [Google Scholar] [CrossRef] [PubMed]
- de Block, T.; Laumen, J.G.E.; van Dijck, C.; Abdellati, S.; de Baetselier, I.; Manoharan-Basil, S.S.; van den Bossche, D.; Kenyon, C. WGS of Commensal Neisseria Reveals Acquisition of a New Ribosomal Protection Protein (MsrD) as a Possible Explanation for High Level Azithromycin Resistance in Belgium. Pathogens 2021, 10, 384. [Google Scholar] [CrossRef]
- Lederberg, J.; Lederberg, E.M. Replica Plating and Indirect Selection of Bacterial Mutants. J. Bacteriol. 1952, 63, 399–406. [Google Scholar] [CrossRef]
- Abdellati, S.; Laumen, J.; Gonzalez, N.; Manoharan-Basil, S.S.; van Dijck, C.; de Baetselier, I.; Martiny, D.; de Block, T.; Kenyon, C. Neisseria mucosa Does Not Inhibit the Growth of Neisseria gonorrhoeae. Sci 2022, 4, 8. [Google Scholar] [CrossRef]
- Aho, E.L.; Ogle, J.M.; Finck, A.M. The Human Microbiome as a Focus of Antibiotic Discovery: Neisseria mucosa Displays Activity Against Neisseria gonorrhoeae. Front Microbiol. 2020, 11. [Google Scholar] [CrossRef]
- U.S. Food and Drug Administration. Microorganisms & Microbial-Derived Ingredients Used in Food (Partial List). Available online: https://www.fda.gov/food/generally-recognized-safe-gras/microorganisms-microbial-derived-ingredients-used-food-partial-list#:~:text=Food%20ingredients%20may%20be%20%22food,the%20safety%20of%20the%20substance (accessed on 6 November 2022).
- International Dairy Federation. Bulletin of the IDF N° 377/2002—Health Benefits and Safety Evaluation of Certain Food Components. Available online: https://www.fil-idf.org/wp-content/uploads/woocommerce_uploads/2002/03/B377_2002_Health-Benefits-and-Safety-Evaluation-of-Certain-Food-Components-Secured-7ajr9v.pdf (accessed on 6 November 2022).
- Santagati, M.; Scillato, M.; Patanè, F.; Aiello, C.; Stefani, S. Bacteriocin-producing oral streptococci and inhibition of respiratory pathogens. FEMS Immunol. Med. Microbiol. 2012, 65, 23–31. [Google Scholar] [CrossRef]
- Janier, M.; Lassau, F.; Casin, I.; Morel, P. Pharyngeal gonorrhoea: The forgotten reservoir. Sex. Transm. Infect. 2003, 79, 345. [Google Scholar] [CrossRef] [PubMed][Green Version]
- BISAILLON, J.-G.; TURGEON, P.; DUBREUIL, D.; BEAUDET, R.; SYLVESTRE, M.; ASHTON, F.E. In Vitro Inhibition of Growth of Neisseria gonorrhoeae by Neisseria meningitidis Isolated from the Pharynx of Homosexual Men. Sex. Transm. Dis. 1984, 11, 296–300. [Google Scholar] [CrossRef] [PubMed]
- McBride, M.E.; Duncan, W.C.; Knox, J.M. Bacterial interference of Neisseria gonorrhoeae by alpha-haemolytic streptococci. Sex. Transm. Infect. 1980, 56, 235–238. [Google Scholar] [CrossRef] [PubMed]
- Bisaillon, J.G.; Beaudet, R.; Lafond, L.; Saheb, S.A.; Sylvestre, M. Antigonococcal and antibacterial spectra of some bacterial isolates of the urogenital flora. Rev. Can. Biol. 1981, 40, 215–227. [Google Scholar]
- Zipperer, A.; Konnerth, M.C.; Laux, C.; Berscheid, A.; Janek, D.; Weidenmaier, C.; Burian, M.; Schilling, N.A.; Slavetinsky, C.; Marschal, M.; et al. Human commensals producing a novel antibiotic impair pathogen colonization. Nature 2016, 535, 511–516. [Google Scholar] [CrossRef]
- Walker, S.; Bellhouse, C.; Fairley, C.K.; Bilardi, J.E.; Chow, E.P.F. Pharyngeal Gonorrhoea: The Willingness of Australian Men Who Have Sex with Men to Change Current Sexual Practices to Reduce Their Risk of Transmission—A Qualitative Study. PLoS ONE 2016, 11, e0164033. [Google Scholar] [CrossRef]
- Cornelisse, V.J.; Fairley, C.K.; Walker, S.; Young, T.; Lee, D.; Chen, M.Y.; Bradshaw, C.S.; Chow, E.P.F. Adherence to, and acceptability of, Listerine® mouthwash as a potential preventive intervention for pharyngeal gonorrhoea among men who have sex with men in Australia: A longitudinal study. Sex. Health 2016, 13, 494. [Google Scholar] [CrossRef]
- Chow, E.P.; Howden, B.P.; Walker, S.; Lee, D.; Bradshaw, C.S.; Chen, M.Y.; Snow, A.; Cook, S.; Fehler, G.; Fairley, C.K. Antiseptic mouthwash against pharyngeal Neisseria gonorrhoeae: A randomised controlled trial and an in vitro study. Sex. Transm. Infect. 2017, 93, 88–93. [Google Scholar] [CrossRef]
- Laumen, J.G.E. The Effect of Daily Usage of Listerine Mouthwash on the Pharyngeal Microbiome. Available online: https://online.eccmid.org/container-intervention-lookup.php?p=1&interv=P1182 (accessed on 2 November 2022).
- Zaura, E.; Keijser, B.J.; Huse, S.M.; Crielaard, W. Defining the healthy “core microbiome” of oral microbial communities. BMC Microbiol. 2009, 9, 259. [Google Scholar] [CrossRef]
- Deasy, A.M.; Guccione, E.; Dale, A.P.; Andrews, N.; Evans, C.M.; Bennett, J.S.; Bratcher, H.B.; Maiden, M.C.J.; Gorringe, A.R.; Read, R.C. Nasal Inoculation of the Commensal Neisseria lactamica Inhibits Carriage of Neisseria meningitidis by Young Adults: A Controlled Human Infection Study. Clin. Infect. Dis. 2015, 60, 1512–1520. [Google Scholar] [CrossRef]

| Species | Strain | AZM MIC | AZM | CRO MIC | CRO | Source |
|---|---|---|---|---|---|---|
| N. gonorrhoeae | WHO P | 4 | R | 0.004 | S | Unemo et al. (2016) [28] |
| N. meningitidis | MO0003/1 | 1 | S | <0.016 | S | de Block et al. (2021) [29] |
| Isolate | Frequency | Percent |
|---|---|---|
| Rothia dentocariosa | 2 | 3.2 |
| Rothia mucilaginosa | 1 | 1.6 |
| Streptococcus cristatus | 4 | 6.5 |
| Streptococcus dysgalactiae | 3 | 4.8 |
| Streptococcus gordonii | 1 | 1.6 |
| Streptococcus infantis | 1 | 1.6 |
| Streptococcus mitis | 8 | 12.9 |
| Streptococcus oralis | 5 | 8.1 |
| Streptococcus parasanguinis | 14 | 22.6 |
| Streptococcus peroris | 1 | 1.6 |
| Streptococcus pyogenes | 6 | 9.7 |
| Streptococcus salivarius | 4 | 6.5 |
| Streptococcus sanguinis | 10 | 16.1 |
| Streptococcus vestibularis | 2 | 3.2 |
| Total | 62 | 100 |
| Isolate | Frequency in Baseline | Frequency in Treatment |
|---|---|---|
| Rothia mucilaginosa | 1 | 0 |
| Rothia dentocariosa | 0 | 2 |
| Streptococcus cristatus | 3 | 1 |
| Streptococcus dysgalactiae | 2 | 1 |
| Streptococcus gordonii | 0 | 1 |
| Streptococcus infantis | 0 | 1 |
| Streptococcus mitis | 4 | 4 |
| Streptococcus oralis | 2 | 3 |
| Streptococcus parasanguinis | 3 | 11 |
| Streptococcus peroris | 0 | 1 |
| Streptococcus pyogenes | 1 | 5 |
| Streptococcus salivarius | 3 | 1 |
| Streptococcus sanguinis | 4 | 6 |
| Streptococcusvestibularis | 0 | 2 |
Publisher’s Note: MDPI stays neutral with regard to jurisdictional claims in published maps and institutional affiliations. |
© 2022 by the authors. Licensee MDPI, Basel, Switzerland. This article is an open access article distributed under the terms and conditions of the Creative Commons Attribution (CC BY) license (https://creativecommons.org/licenses/by/4.0/).
Share and Cite
Akomoneh, E.A.; Laumen, J.G.E.; Abdellati, S.; Van Dijck, C.; Vanbaelen, T.; Britto, X.B.; Manoharan-Basil, S.S.; Kenyon, C. The Discovery of Oropharyngeal Microbiota with Inhibitory Activity against Pathogenic Neisseria gonorrhoeae and Neisseria meningitidis: An In Vitro Study of Clinical Isolates. Microorganisms 2022, 10, 2497. https://doi.org/10.3390/microorganisms10122497
Akomoneh EA, Laumen JGE, Abdellati S, Van Dijck C, Vanbaelen T, Britto XB, Manoharan-Basil SS, Kenyon C. The Discovery of Oropharyngeal Microbiota with Inhibitory Activity against Pathogenic Neisseria gonorrhoeae and Neisseria meningitidis: An In Vitro Study of Clinical Isolates. Microorganisms. 2022; 10(12):2497. https://doi.org/10.3390/microorganisms10122497
Chicago/Turabian StyleAkomoneh, Elvis Achondou, Jolein Gyonne Elise Laumen, Saïd Abdellati, Christophe Van Dijck, Thibau Vanbaelen, Xavier Basil Britto, Sheeba S. Manoharan-Basil, and Chris Kenyon. 2022. "The Discovery of Oropharyngeal Microbiota with Inhibitory Activity against Pathogenic Neisseria gonorrhoeae and Neisseria meningitidis: An In Vitro Study of Clinical Isolates" Microorganisms 10, no. 12: 2497. https://doi.org/10.3390/microorganisms10122497
APA StyleAkomoneh, E. A., Laumen, J. G. E., Abdellati, S., Van Dijck, C., Vanbaelen, T., Britto, X. B., Manoharan-Basil, S. S., & Kenyon, C. (2022). The Discovery of Oropharyngeal Microbiota with Inhibitory Activity against Pathogenic Neisseria gonorrhoeae and Neisseria meningitidis: An In Vitro Study of Clinical Isolates. Microorganisms, 10(12), 2497. https://doi.org/10.3390/microorganisms10122497

